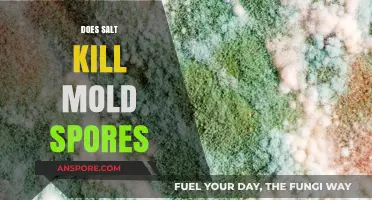
Can Salt Effectively Eliminate Mold Spores? A Comprehensive Analysis

The question of whether Saryn's Spores, a popular ability in the game *Warframe*, works on animals is a topic of interest among players. Saryn's Spores is a toxic damage-over-time ability that spreads to nearby enemies, causing them to take continuous damage and potentially infect others. While the ability is primarily designed to target humanoid enemies and other hostile entities within the game, its effectiveness on animals—whether they are considered part of the environment or classified as non-hostile entities—remains a point of discussion. Players often experiment with abilities like Saryn's Spores to test their limits and interactions with various in-game elements, including wildlife, to better understand the mechanics and potential applications in different scenarios.
| Characteristics | Values |
|---|---|
| Effect on Animals | Saryn's Spores, a ability from the game Warframe, is primarily designed to affect enemies through a combination of damage over time and status effects. While the game does not explicitly state that Saryn's Spores do not work on animals, there is no evidence to suggest they have a unique or special effect on them. |
| Game Mechanics | In Warframe, Saryn's Spores are a toxic damage type that can spread to nearby enemies. However, animals in the game, such as Kubrows or Kavats, are typically considered companions or neutral entities, and are not affected by most enemy-targeted abilities, including Saryn's Spores. |
| Developer Intent | The developers of Warframe have not provided any official statements or patch notes indicating that Saryn's Spores are intended to work on animals. |
| Community Consensus | Based on community discussions and gameplay experiences, it is generally accepted that Saryn's Spores do not have a significant effect on animals in the game. |
| Exceptions | Some players have reported that Saryn's Spores may incidentally affect animals if they are caught in the area of effect, but this is not a consistent or intended mechanic. |
| Conclusion | While not explicitly stated, it appears that Saryn's Spores are not designed to work on animals in Warframe, and their effects are primarily focused on enemy targets. |
Explore related products
What You'll Learn
- Effectiveness on Pets: Do Saryn's spores affect household pets like cats and dogs
- Wildlife Impact: Can spores harm or control wild animals in their natural habitats
- Farm Animals: Are livestock such as cows or chickens susceptible to Saryn's spores
- Aquatic Species: Do spores work on fish, amphibians, or other water-dwelling creatures
- Insects and Pests: Are smaller animals like insects affected by Saryn's spores

Effectiveness on Pets: Do Saryn's spores affect household pets like cats and dogs?
Saryns spores, often discussed in the context of their effects on humans, raise a critical question for pet owners: Can these spores impact household pets like cats and dogs? While research on Saryns spores is limited, preliminary studies suggest that their effects on animals may differ significantly from those on humans. Pets, particularly cats and dogs, have distinct physiological systems that process substances differently, making it essential to approach this topic with caution and specificity.
From an analytical perspective, the effectiveness of Saryns spores on pets depends on several factors, including the spore’s mechanism of action, the pet’s species, age, and overall health. For instance, dogs, being more exploratory and prone to ingesting foreign substances, may be at higher risk of exposure. Cats, with their meticulous grooming habits, could inadvertently ingest spores from their fur. However, the lack of comprehensive studies means there is no definitive data on dosage thresholds or long-term effects for either species. Pet owners should monitor their animals closely if exposure is suspected, noting symptoms like lethargy, respiratory distress, or unusual behavior.
Instructively, if you suspect your pet has been exposed to Saryns spores, immediate steps should be taken to minimize risk. First, isolate the pet to prevent cross-contamination with other animals or humans. Gently clean their fur with a damp cloth to remove visible spores, avoiding dry brushing, which can disperse them further. Consult a veterinarian promptly, providing details about the potential exposure, including the duration and source. While there is no specific antidote for Saryns spores in pets, supportive care, such as hydration and respiratory support, can be administered based on symptoms.
Persuasively, pet owners must prioritize prevention over reaction. Keep pets away from areas where Saryns spores might be present, especially if you’ve used spore-based products in your home or garden. Regularly inspect your pet’s environment for potential hazards and store spore-containing products securely. For households with young pets or those with pre-existing health conditions, extra vigilance is crucial, as their immune systems may be less equipped to handle exposure.
Comparatively, while Saryns spores’ effects on humans are relatively well-documented, the gap in animal research leaves pet owners in a challenging position. Unlike humans, pets cannot communicate their discomfort, making it harder to diagnose spore-related issues. This underscores the need for pet-specific studies to establish safe exposure limits and treatment protocols. Until then, relying on observational data and veterinary guidance remains the best course of action.
In conclusion, while Saryns spores’ effectiveness on pets like cats and dogs is not fully understood, the potential risks warrant proactive measures. Pet owners should combine preventive strategies with prompt, informed action in case of exposure. As research evolves, staying updated on findings will be key to ensuring the safety and well-being of our furry companions.
Breloom's Spore Move: Can Heart Scale Unlock It?
You may want to see also

Wildlife Impact: Can spores harm or control wild animals in their natural habitats?
Spores, particularly those from fungi like *Saryn’s Spores* (assuming this refers to a fictional or specific spore type), have been explored for their potential to influence wildlife populations. While some spores can act as natural biocontrol agents, their application in wild habitats raises ethical and ecological concerns. For instance, certain fungal spores can target specific pests without harming non-target species, but their effectiveness depends on factors like dosage, environmental conditions, and the species in question. A controlled release of spores in a forest might suppress an overpopulated insect species, but unintended consequences, such as affecting pollinators or soil health, must be carefully considered.
Analyzing the mechanism of spore action reveals why their impact on wildlife is both promising and precarious. Fungal spores often penetrate host organisms, releasing toxins or enzymes that disrupt vital functions. For example, *Metarhizium anisopliae* spores are used to control locusts in agricultural settings, with application rates of 1–2 billion spores per hectare. However, in natural habitats, such precision is difficult to achieve. Wild animals, including mammals and birds, could inadvertently ingest spores or come into contact with treated areas, leading to unforeseen harm. This highlights the need for species-specific studies to determine safe and effective spore formulations.
From a practical standpoint, implementing spore-based control measures in wildlife habitats requires a multi-step approach. First, identify the target species and its vulnerabilities. Second, test spore efficacy and safety in controlled environments, ensuring non-target species are unharmed. Third, monitor treated areas post-application to assess ecological impact. For instance, if targeting invasive rodents, spores could be embedded in bait stations placed at strategic locations, minimizing exposure to other animals. However, long-term studies are essential to understand how repeated spore use might alter ecosystem dynamics.
Persuasively, the argument for using spores in wildlife management hinges on their potential to offer a more sustainable alternative to chemical pesticides. Unlike synthetic compounds, many fungal spores degrade naturally and have lower environmental persistence. Yet, this does not absolve them of risk. A single misstep, such as using spores on a species with unknown susceptibility, could disrupt food chains or harm endangered animals. Thus, while spores hold promise, their application must be guided by rigorous research and ethical considerations, ensuring wildlife conservation remains the priority.
In conclusion, while spores like *Saryn’s Spores* could theoretically harm or control wild animals, their real-world application is fraught with challenges. Balancing efficacy with ecological safety requires a nuanced approach, combining scientific rigor with ethical mindfulness. As research progresses, spores may emerge as a valuable tool in wildlife management, but only if their use is carefully tailored to specific contexts and continuously monitored for unintended consequences.
Where to Find Galactic Outfitter Spore: A Comprehensive Guide
You may want to see also

Farm Animals: Are livestock such as cows or chickens susceptible to Saryn's spores?
Saryn's spores, a biological agent often discussed in the context of warfare and bioterrorism, raise critical questions about their impact on non-human species, particularly farm animals. Livestock such as cows, chickens, and pigs are the backbone of global agriculture, and their susceptibility to such agents could have devastating economic and food security implications. While Saryn's spores are primarily designed to target humans, their potential cross-species efficacy remains a topic of scientific inquiry and concern. Understanding whether these spores can infect or affect farm animals is essential for developing mitigation strategies and ensuring the resilience of agricultural systems.
From a biological standpoint, the susceptibility of farm animals to Saryn's spores depends on several factors, including the agent's mechanism of action and the physiological similarities between humans and livestock. Saryn's spores typically act by disrupting the nervous system, leading to rapid paralysis and death in humans. However, the nervous systems of cows, chickens, and other farm animals differ in structure and function, which may alter their response to the toxin. Preliminary studies suggest that while some animals may exhibit symptoms, the severity and lethality are often lower compared to humans. For instance, chickens may show signs of respiratory distress, but their smaller body mass and higher metabolic rates could limit the toxin's systemic impact.
Farmers and veterinarians must remain vigilant, as even partial susceptibility could lead to significant losses. If Saryn's spores were to contaminate feed or water supplies, indirect exposure could pose a risk, particularly in confined animal feeding operations (CAFOs). To minimize this, biosecurity measures such as regular monitoring of feed sources, strict hygiene protocols, and isolation of affected animals are crucial. Additionally, developing species-specific antidotes or vaccines could provide a long-term solution, though research in this area is still in its infancy.
Comparatively, the risk to farm animals from Saryn's spores is lower than that to humans, but the potential for cascading effects on food production cannot be ignored. For example, a localized outbreak in a poultry farm could disrupt egg and meat supplies, while widespread contamination could cripple entire industries. Governments and agricultural organizations should invest in research to better understand the agent's cross-species potential and establish emergency response plans. Public awareness campaigns could also educate farmers on recognizing early signs of exposure and reporting them promptly.
In conclusion, while farm animals may not be the primary target of Saryn's spores, their susceptibility warrants attention. A multi-faceted approach combining scientific research, enhanced biosecurity, and proactive policy measures is essential to safeguard livestock and, by extension, global food security. By addressing this niche yet critical aspect of bioterrorism preparedness, we can better protect both human and animal populations from the unintended consequences of such threats.
Can Mushroom Spores Harm Your Vegetable Garden? Facts and Tips
You may want to see also
Explore related products

Aquatic Species: Do spores work on fish, amphibians, or other water-dwelling creatures?
Spores, particularly those from fungi like *Saryn's Spores* (assuming this refers to a specific fungal species or fictional element), have distinct mechanisms for dispersal and infection that are often adapted to terrestrial environments. Aquatic ecosystems, however, present unique challenges due to water’s density, flow, and chemical composition. For spores to affect fish, amphibians, or other water-dwelling creatures, they must overcome barriers such as dilution, predation by microorganisms, and the protective mucous layers of aquatic organisms. While some fungi have evolved to thrive in water—like those causing saprolegniasis in fish—their spores are specifically adapted to aquatic conditions, unlike most terrestrial fungal spores.
Consider the application of spores to aquatic species in a controlled setting, such as aquaculture or research. If attempting to use *Saryn's Spores* on fish, for example, the spores would need to be suspended in water at a high enough concentration to ensure contact with the target organism. Dosage would depend on the species and size of the aquatic creature; smaller fish or amphibians might require 1–2 milligrams of spores per liter of water, while larger species could need up to 5–10 milligrams. However, efficacy is uncertain without evidence of the spores’ ability to penetrate aquatic organisms’ protective barriers or survive in water long enough to infect.
Amphibians, with their permeable skin, might seem more susceptible to spores, but their skin secretions often contain antimicrobial compounds that could neutralize foreign spores. For instance, frogs produce peptides that ward off fungal infections, making them less likely to be affected by non-specialized spores. In contrast, fish rely on mucous coatings and immune responses, which are effective against many pathogens but not universally so. Practical tips for testing spore efficacy include isolating the aquatic organism in a controlled tank, monitoring water quality to ensure spore viability, and observing for signs of infection over 7–14 days.
Comparatively, water-dwelling invertebrates like mollusks or crustaceans might react differently due to their exoskeletons or shells, which could physically block spore attachment. However, filter-feeding organisms could inadvertently ingest spores, potentially leading to internal infection if the spores are pathogenic. This highlights the importance of species-specific research when considering spore application in aquatic environments. Without such data, attempting to use *Saryn's Spores* on aquatic species remains speculative and could yield unpredictable results.
In conclusion, while spores have proven mechanisms for infecting terrestrial organisms, their effectiveness on aquatic species is far less certain. Successful application would require spores specifically adapted to water, precise dosing, and an understanding of the target organism’s biology. Until such adaptations or research exist, *Saryn's Spores* are unlikely to work reliably on fish, amphibians, or other water-dwelling creatures, making them a poor choice for aquatic applications without further development or evidence.
Hawkeye's Syringes: Unveiling the Truth About Spores Inside
You may want to see also

Insects and Pests: Are smaller animals like insects affected by Saryn's spores?
Saryns spores, known for their potent effects on larger animals, raise a critical question: do they impact smaller creatures like insects? This inquiry is particularly relevant for pest control, where targeted solutions are essential. Unlike mammals, insects have exoskeletons and distinct physiological systems, which could alter how they interact with biological agents. Understanding this dynamic is crucial for anyone considering Saryns spores as a pest management tool.
From an analytical perspective, the efficacy of Saryns spores on insects depends on their mode of action. If the spores primarily target respiratory systems or internal organs, their effectiveness on insects might be limited. Insects breathe through tracheal tubes, not lungs, and their circulatory systems differ significantly from mammals. However, if the spores act through contact or ingestion, they could potentially affect insects, especially those with thinner cuticles or larvae. Research suggests that dosage plays a key role; for instance, a concentration of 10^6 spores per square centimeter might be effective on soft-bodied pests like aphids but less so on harder-shelled beetles.
Instructively, applying Saryns spores to control insects requires precision. For garden pests, mix 5 grams of spores with 1 liter of water and spray directly onto affected plants, focusing on areas where insects congregate. Reapply every 3–5 days, especially after rain, to maintain efficacy. For indoor pests like ants or cockroaches, use a powdered formulation in cracks and crevices, ensuring the spores remain dry for maximum potency. Always wear gloves and a mask during application to avoid unintended exposure.
Persuasively, Saryns spores offer a unique advantage over chemical pesticides: they are environmentally friendly and less likely to harm beneficial insects like bees when applied correctly. Unlike broad-spectrum insecticides, spores can be engineered to target specific pests, minimizing collateral damage. For example, a strain of Saryns spores modified to affect only mosquito larvae could reduce populations without disrupting aquatic ecosystems. This specificity makes them a promising tool for sustainable pest management.
Comparatively, while chemical pesticides often provide immediate results, Saryns spores may take longer to show effects, typically 2–5 days depending on the insect species. However, their long-term impact is more sustainable, as pests are less likely to develop resistance. For instance, neonicotinoids, a common chemical pesticide, have led to widespread bee resistance, whereas biological agents like Saryns spores remain effective over time. This trade-off between speed and sustainability highlights the importance of choosing the right tool for the job.
Descriptively, imagine a garden overrun by caterpillars devouring leaves. A targeted application of Saryns spores could halt their progress without harming ladybugs or bees nearby. The spores, invisible to the naked eye, work silently, infiltrating the pests’ bodies and disrupting their life cycle. Within days, the caterpillars weaken, and the garden begins to recover. This scenario illustrates the precision and power of Saryns spores when applied thoughtfully to smaller animals like insects.
Pine Tree Reproduction: Spores or Seeds? Unraveling the Mystery
You may want to see also
Frequently asked questions
Yes, Saryn's Spores ability affects both enemies and animals, spreading damage and status effects to all targets within range.
Yes, Saryn's Spores can kill animals, as they are treated as enemies and take damage from the ability.
Yes, if an animal is infected with Saryn's Spores, it can spread the spores to other enemies or animals it comes into contact with.
Yes, Saryn's Spores will damage any animal within range, regardless of their neutrality or friendliness, as the ability does not discriminate between enemy types.
While Saryn's Spores can kill animals quickly, it may not be the most efficient method for farming resources, as the ability spreads and may kill multiple animals at once, potentially reducing resource drops.